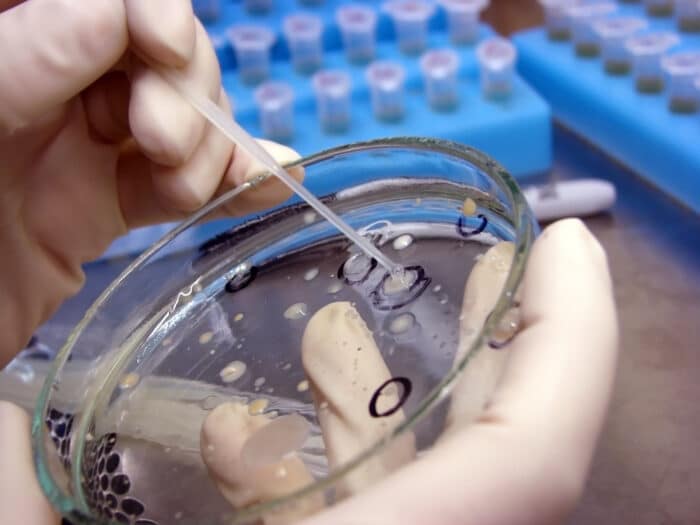

MENUMENU
- Отделения
- Диагнозы
- Процедуры
- Специалисты
- Отзывы
- Пациентам
- Блог
- Контакты


Современная онкология всё чаще выходит за рамки классификации опухолей по органам. Сегодня мы говорим о молекулярных подтипах рака, об их уникальных транскриптомах, сигнальных путях и маркёрах. Один из таких маркёров – FOLR1, или фолатный рецептор альфа (Folate Receptor Alpha). Он неожиданно оказался не просто вспомогательной “антенной” для витаминов, а важной частью профиля опухолей – особенно в панораме всех видов рака (pan-cancer).
FOLR1 – это мембранный белок, участвующий в транспортировке фолатов (витаминов группы B) в клетки. Фолаты необходимы для синтеза ДНК и деления клеток, что делает этот рецептор особенно активным в быстрорастущих тканях – включая опухоли.
У здорового человека FOLR1 почти не экспрессируется в зрелых тканях, за исключением плаценты и некоторых эпителиальных клеток. Но в опухолях его активность может резко возрастать – что делает его интересной мишенью как для диагностики, так и для терапии.
Недавние pan-cancer исследования – когда анализируют сотни видов рака разных органов одновременно – показали: высокая экспрессия FOLR1 характерна не для всех опухолей, а только для определённой группы с уникальным транскриптомным профилем. То есть с особым «языком» экспрессии генов.
Что это за опухоли?
Объединяет их не орган происхождения, а общая молекулярная “подпись”: повышенная активность генов, отвечающих за клеточное деление, митоз, метаболизм фолатов и угнетение иммунного ответа.
Исследования с использованием данных TCGA (The Cancer Genome Atlas) и других открытых баз показывают: экспрессия FOLR1 коррелирует с определённым транскриптомным профилем. Такие опухоли могут быть более чувствительны к:
Таким образом, тест на экспрессию FOLR1 может стать частью более широкой стратегии молекулярной диагностики.
FOLR1 – это не просто белок. Это “ключ”, который помогает открыть дверь в скрытую архитектуру опухоли. Вместо того чтобы делить рак только по органам, мы начинаем видеть новые, пан-органные классы опухолей, связанные общими механизмами роста и устойчивости.
И, возможно, именно такие молекулярные ключи, как FOLR1, в будущем станут отправной точкой для абсолютно новой онкологии — той, что лечит не «рак яичника» или «рак лёгкого», а конкретный транскриптом, конкретную мишень, конкретную уязвимость.